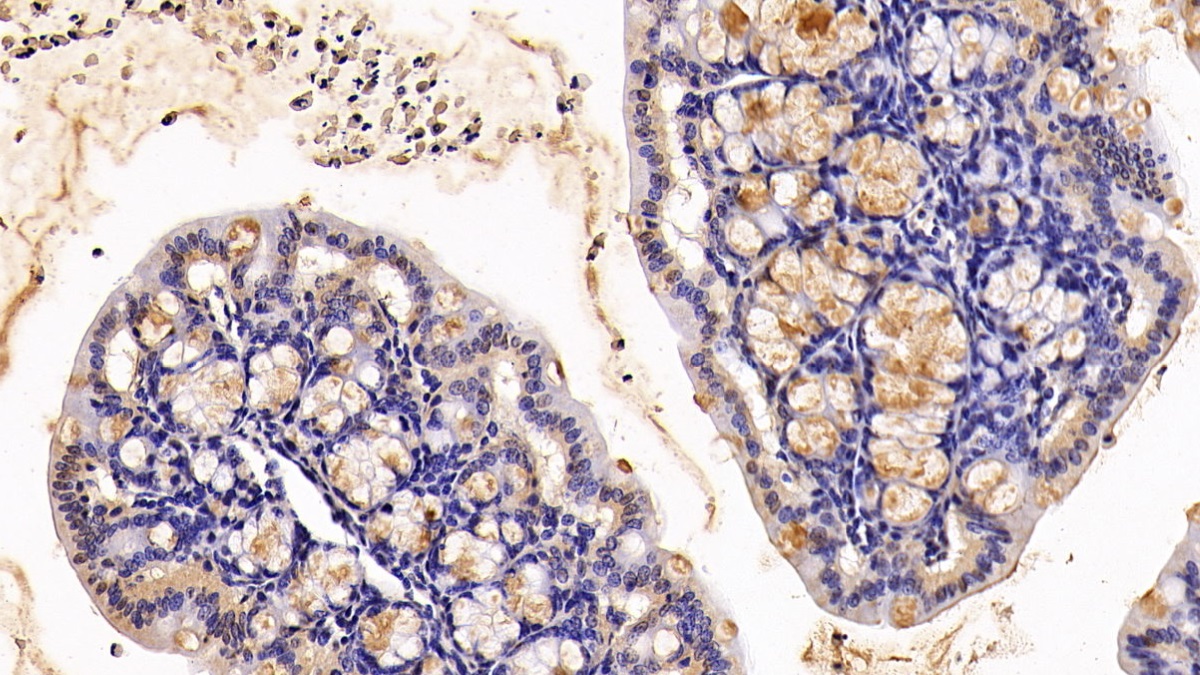

Polyclonal Antibody to Mucin 2 (MUC2)
MLP; SMUC; Oligomeric Mucus/Gel-Forming; Mucin 2,Intestinal/Tracheal
- Product No.PAA705Mu01
- Organism SpeciesMus musculus (Mouse) Same name, Different species.
- SourcePolyclonal antibody preparation
- HostRabbit
- Potencyn/a
- Ig Type IgG
- PurificationAntigen-specific affinity chromatography followed by Protein A affinity chromatography
- LabelNone
- Immunogen RPA705Mu01-Recombinant Mucin 2 (MUC2)
- Buffer Formulation0.01M PBS, pH7.4, containing 0.05% Proclin-300, 50% glycerol.
- TraitsLiquid
- Concentration0.5mg/mL
- Organism Species MoreRattus norvegicus (Rat)
- ApplicationsWB; IHC
If the antibody is used in flow cytometry, please check FCM antibodies. - DownloadInstruction Manual
- UOM 20µl100µl 200µl 1ml 10ml
- FOB
US$ 97
US$ 227
US$ 324
US$ 810
US$ 3240
For more details, please contact local distributors!
SPECIFITY
The antibody is a rabbit polyclonal antibody raised against MUC2. It has been selected for its ability to recognize MUC2 in immunohistochemical staining and western blotting.
USAGE
Western blotting: 0.01-2µg/mL;
Immunohistochemistry: 5-20µg/mL;
Optimal working dilutions must be determined by end user.
STORAGE
Store at 4°C for frequent use. Stored at -20°C in a manual defrost freezer for two year without detectable loss of activity. Avoid repeated freeze-thaw cycles.
STABILITY
The thermal stability is described by the loss rate. The loss rate was determined by accelerated thermal degradation test, that is, incubate the protein at 37°C for 48h, and no obvious degradation and precipitation were observed. The loss rate is less than 5% within the expiration date under appropriate storage condition.
GIVEAWAYS
INCREMENT SERVICES
-
 Antibody Labeling Customized Service
Antibody Labeling Customized Service
-
 Protein A/G Purification Column
Protein A/G Purification Column
-
 Staining Solution for Cells and Tissue
Staining Solution for Cells and Tissue
-
 Positive Control for Antibody
Positive Control for Antibody
-
 Tissue/Sections Customized Service
Tissue/Sections Customized Service
-
 Phosphorylated Antibody Customized Service
Phosphorylated Antibody Customized Service
-
 Western Blot (WB) Experiment Service
Western Blot (WB) Experiment Service
-
 Immunohistochemistry (IHC) Experiment Service
Immunohistochemistry (IHC) Experiment Service
-
 Immunocytochemistry (ICC) Experiment Service
Immunocytochemistry (ICC) Experiment Service
-
 Flow Cytometry (FCM) Experiment Service
Flow Cytometry (FCM) Experiment Service
-
 Immunoprecipitation (IP) Experiment Service
Immunoprecipitation (IP) Experiment Service
-
 Immunofluorescence (IF) Experiment Service
Immunofluorescence (IF) Experiment Service
-
 Buffer
Buffer
-
 DAB Chromogen Kit
DAB Chromogen Kit
-
 SABC Kit
SABC Kit
-
 Long-arm Biotin Labeling Kit
Long-arm Biotin Labeling Kit
-
 Real Time PCR Experimental Service
Real Time PCR Experimental Service
| Magazine | Citations |
| Annals of surgical oncology | Pancreatic cyst fluid and serum mucin levels predict dysplasia in intraductal papillary mucinous neoplasms of the pancreas. PubMed: 20717734 |
| World J Gastroenterol. | Sodium alginate ameliorates indomethacin-induced gastrointestinal mucosal injury via inhibiting translocation in rats. Pubmed:24627600 |
| Front Microbiol | Fecal microbiota transplantation and bacterial consortium transplantation have comparable effects on the re-establishment of mucosal barrier function in mice with intestinal dysbiosis PubMed: 26217323 |
| nutrition research and practice | Butyrate modulates bacterial adherence on LS174T human colorectal cells by stimulating mucin secretion and MAPK signaling pathway PubMed: 26244071 |
| Respirology | Secreted mucins and airway bacterial colonization in non-CF bronchiectasis PubMed: 26172851 |
| Ann Am Thorac Soc | Airway Mucin 2 Is Decreased in Patients with Severe Chronic Obstructive Pulmonary Disease with Bacterial Colonization doi:10.1513 |
| Cellular Microbiology | An adherent mucus layer attenuates the genotoxic effect of colibactin. pubmed:29156489 |
| Bio-protocol | Enhancement of Mucus Production in Eukaryotic Cells and Quantification of Adherent Mucus by ELISA 10.21769:BioProtoc.2879 |
| Journal of Investigative Medicine | The characteristics and clinical significance of mucin levels in bronchoalveolar lavage fluid of patients with interstitial lung disease Pubmed: 30573494 |
| Biomolecules | Clinical Significance of Serum Membrane-Bound Mucin-2 Levels in Breast Cancer Pubmed: 30682816 |
| Cell Stem Cell | PRDM16 Maintains Homeostasis of the Intestinal Epithelium by Controlling Region-Specific Metabolism Pubmed: 31564549 |
| DIGESTIVE DISEASES AND SCIENCES | Compromised Ileal Mucus Barrier Due to Impaired Epithelial Homeostasis Caused by Notch1 Signaling in Cirrhotic Rats Pubmed: 32144600 |
| Scientific Reports | Mucus layer modeling of human colonoids during infection with enteroaggragative E. coli Pubmed: 32601325 |
| Biorxiv | Defective intestinal repair after short-term high fat diet due to loss of efferocytosis |
| J Cell Mol Med | Inhibition of cyclooxygenase©\2 enhanced intestinal epithelial homeostasis via suppressing ¦Â©\catenin signalling pathway in experimental liver fibrosis 34145945 |
| Cell Tissue Res | Reduced acetylcholine and elevated muscarinic receptor 2 in duodenal mucosa contribute to the impairment of mucus secretion in 6-hydroxydopamine-induced … 34370080 |
| Catalog No. | Related products for research use of Mus musculus (Mouse) Organism species | Applications (RESEARCH USE ONLY!) |
| RPA705Mu02 | Recombinant Mucin 2 (MUC2) | Positive Control; Immunogen; SDS-PAGE; WB. |
| RPA705Mu03 | Recombinant Mucin 2 (MUC2) | Positive Control; Immunogen; SDS-PAGE; WB. |
| RPA705Mu01 | Recombinant Mucin 2 (MUC2) | Positive Control; Immunogen; SDS-PAGE; WB. |
| PAA705Mu02 | Polyclonal Antibody to Mucin 2 (MUC2) | WB |
| PAA705Mu03 | Polyclonal Antibody to Mucin 2 (MUC2) | WB; IHC; ICC; IP. |
| PAA705Mu01 | Polyclonal Antibody to Mucin 2 (MUC2) | WB; IHC |
| LAA705Mu81 | FITC-Linked Polyclonal Antibody to Mucin 2 (MUC2) | WB; IHC; ICC; IF. |
| LAA705Mu71 | Biotin-Linked Polyclonal Antibody to Mucin 2 (MUC2) | WB; IHC; ICC. |
| SEA705Mu | ELISA Kit for Mucin 2 (MUC2) | Enzyme-linked immunosorbent assay for Antigen Detection. |
| LMA705Mu | Multiplex Assay Kit for Mucin 2 (MUC2) ,etc. by FLIA (Flow Luminescence Immunoassay) | FLIA Kit for Antigen Detection. |
| KSA705Mu01 | ELISA Kit DIY Materials for Mucin 2 (MUC2) | Main materials for "Do It (ELISA Kit) Yourself". |